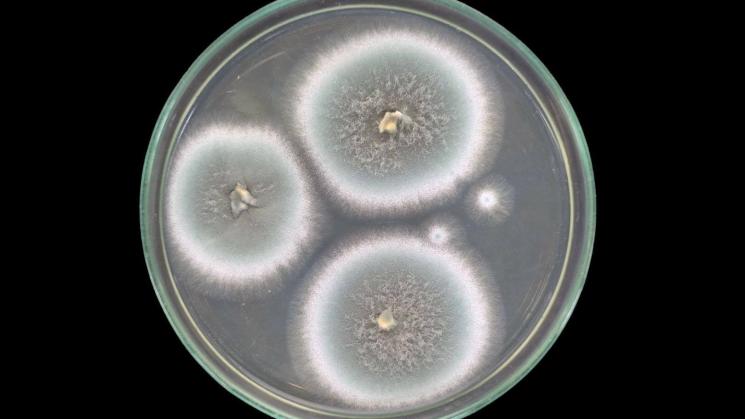
Las infecciones por hongos están aumentando y la gente está empezando a fallecer

Las infecciones por hongos solían considerarse poco comunes, casi anecdóticas. Sin embargo, hoy representan una amenaza creciente para la salud global. Con más de 6,5 millones de casos anuales y cerca de 2,5 millones de muertes, estas enfermedades se han vuelto una crisis silenciosa que la medicina moderna apenas está empezando a reconocer.
Las infecciones pasaron de amenazas raras a epidemia inadvertida
Cuando se habla de infecciones letales, la mayoría piensa en bacterias resistentes o virus emergentes. Pero para médicos como Peter Chin-Hong, especialista en enfermedades infecciosas en la Universidad de California en San Francisco, el verdadero peligro hoy reside en los hongos.
Su experiencia incluye casos impactantes: un joven corredor con una infección cardíaca por Coccidioides, un paciente trasplantado que expulsaba moho desde sus pulmones, y una mujer con diabetes cuyo rostro fue parcialmente destruido por un hongo negro. Historias que antes habrían parecido excepcionales, hoy son cotidianas.
Lo alarmante es que estas infecciones fúngicas invasivas están aumentando en lugares y personas que antes no eran considerados de riesgo. El cambio climático ha ampliado el territorio de muchos hongos patógenos, mientras que los avances médicos —como los trasplantes, la quimioterapia o los tratamientos inmunosupresores— aunque salvan vidas, también dejan a los pacientes más vulnerables a estos organismos.
Además, enfermedades comunes como la diabetes también elevan el riesgo de sufrir infecciones fúngicas severas. Las cifras son contundentes: 6,5 millones de casos cada año, y más de 2,5 millones de muertes, una cifra que duplica las muertes por tuberculosis. Gran parte de estas se producen en personas con VIH avanzado, lo cual se ve agravado por los recortes en los programas globales de atención al SIDA, especialmente en países de bajos recursos donde el diagnóstico y tratamiento son precarios.
Candida auris y la resistencia: un enemigo difícil de combatir

Una de las mayores preocupaciones actuales es el surgimiento de hongos resistentes a los tratamientos. Candida auris, una levadura identificada por primera vez en 2009, ha protagonizado brotes mortales en hospitales de todo el mundo. Este hongo, altamente resistente a los medicamentos, ha puesto en evidencia lo limitado del arsenal antifúngico global.
La situación es tan grave que la Organización Mundial de la Salud (OMS) ha emitido advertencias sobre la falta de capacidad diagnóstica y terapéutica frente a estas infecciones. En la última década, solo se han aprobado cuatro nuevos fármacos antifúngicos en el mundo. De los nueve que actualmente están en desarrollo, apenas tres han llegado a su fase final de estudio en humanos. Y peor aún: más de la mitad de estos candidatos carecen de mecanismos innovadores, lo que reduce drásticamente su efectividad contra cepas resistentes.
Este estancamiento farmacológico contrasta con la velocidad con la que los hongos evolucionan. “Podemos esperar pocas aprobaciones nuevas en los próximos 10 años”, alertó Valeria Gigante, responsable de la división de resistencia a los antimicrobianos de la OMS. Y el problema se agrava cuando estos nuevos medicamentos son utilizados en la agricultura antes que en humanos, acelerando la aparición de resistencia en el ambiente.
La falta de innovación, sumada al uso agrícola de antimicóticos, crea un círculo vicioso peligroso. “Esto es desalentador para quienes desarrollan fármacos para uso humano, y un poco preocupante para la salud pública”, expresó Justin Beardsley, médico e investigador de la Universidad de Sídney. Según él, los hongos siguen fuera del radar, y eso permite que crezcan sin control.
Diagnóstico tardío, tratamientos limitados y muertes prevenibles

Otro punto crítico es el diagnóstico. Aun cuando existen pruebas para identificar hongos peligrosos, su disponibilidad en países de ingresos bajos y medios es limitada. Se requieren laboratorios bien equipados y personal capacitado, un lujo en muchas regiones. Mientras tanto, las infecciones avanzan sin ser detectadas o tratadas a tiempo.
Además, los hongos tienen comportamientos muy distintos a bacterias o virus. Rara vez se transmiten entre personas; en su lugar, provienen del entorno: suelos contaminados, plantas en descomposición o esporas aéreas que incluso pueden recorrer continentes. Esto los convierte en enemigos invisibles, imposibles de contener con métodos tradicionales de prevención.
Las infecciones más graves, como la mucormicosis, son especialmente preocupantes. Esta infección, conocida por causar necrosis en los tejidos, puede alcanzar los pulmones o el cerebro. En los pulmones, la tasa de mortalidad puede llegar al 87%; si invade el cerebro, ronda el 50%. En muchos casos, la única opción es la cirugía radical: extirpación de tejido, incluso de un ojo, si el hongo ha invadido las cavidades sinusales. Y en los pulmones, donde la resección es más complicada, las posibilidades de supervivencia son mínimas.
Para los pacientes inmunodeprimidos —precisamente quienes más dependen de estos tratamientos—, los antifúngicos actuales son muchas veces ineficaces. “Tenemos agentes ahora, pero nos estamos quedando sin ellos”, advierte Chin-Hong. La amenaza ya no es futura: está ocurriendo ahora mismo, en hospitales de todo el mundo.
Las infecciones por hongos invasivas han dejado de ser rarezas médicas y se han convertido en una crisis de salud pública mundial. La falta de tratamientos efectivos, la resistencia creciente y la debilidad de los sistemas de diagnóstico nos están dejando expuestos. Ignorar esta amenaza sería permitir que un enemigo invisible continúe cobrando millones de vidas sin resistencia efectiva.
Referencia:
- OMS/WHO issues its first-ever reports on tests and treatments for fungal infections. Link
Relacionado
Descubre más desde Cerebro Digital
Suscríbete y recibe las últimas entradas en tu correo electrónico.
